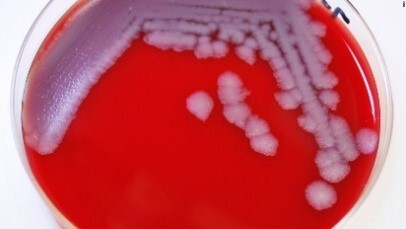
colonies on SBA
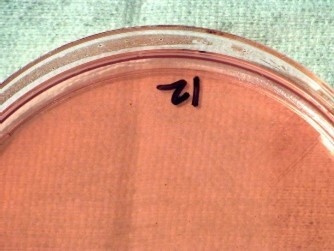
Slow growing on MacConkey
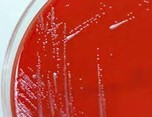
Slow growing on SBA
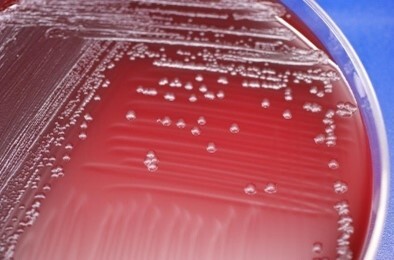
Growth on SBA
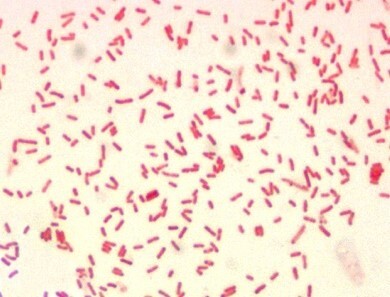
gram-negative rods

Remember: Look through the Lid, Stop, and Consider moving to a BSC if you observe
colonial characteristics as described below!

Rapidly growing, large ground glass colonies on SBA with large gram positive rods. Possible: Bacillus anthracis or B. cereus var anthracis.

Slow growing, tiny gram-negative rods or coccobacilli especially with no growth on MacConkey. Possible: Francisella Tularensis or Brucella spp.

Slow growing bacteria with seem to have no clear Gram stain morphology (may appear as amorphous dust). Possible: Francisella tularensis.

Slow growing gram-negative rods needing 48-72 hours incubation. Possible: Yersinia pestis and Burkholderia spp.

Fat gram-negative rods with bipolar staining. Possible: Yersinia pestis.